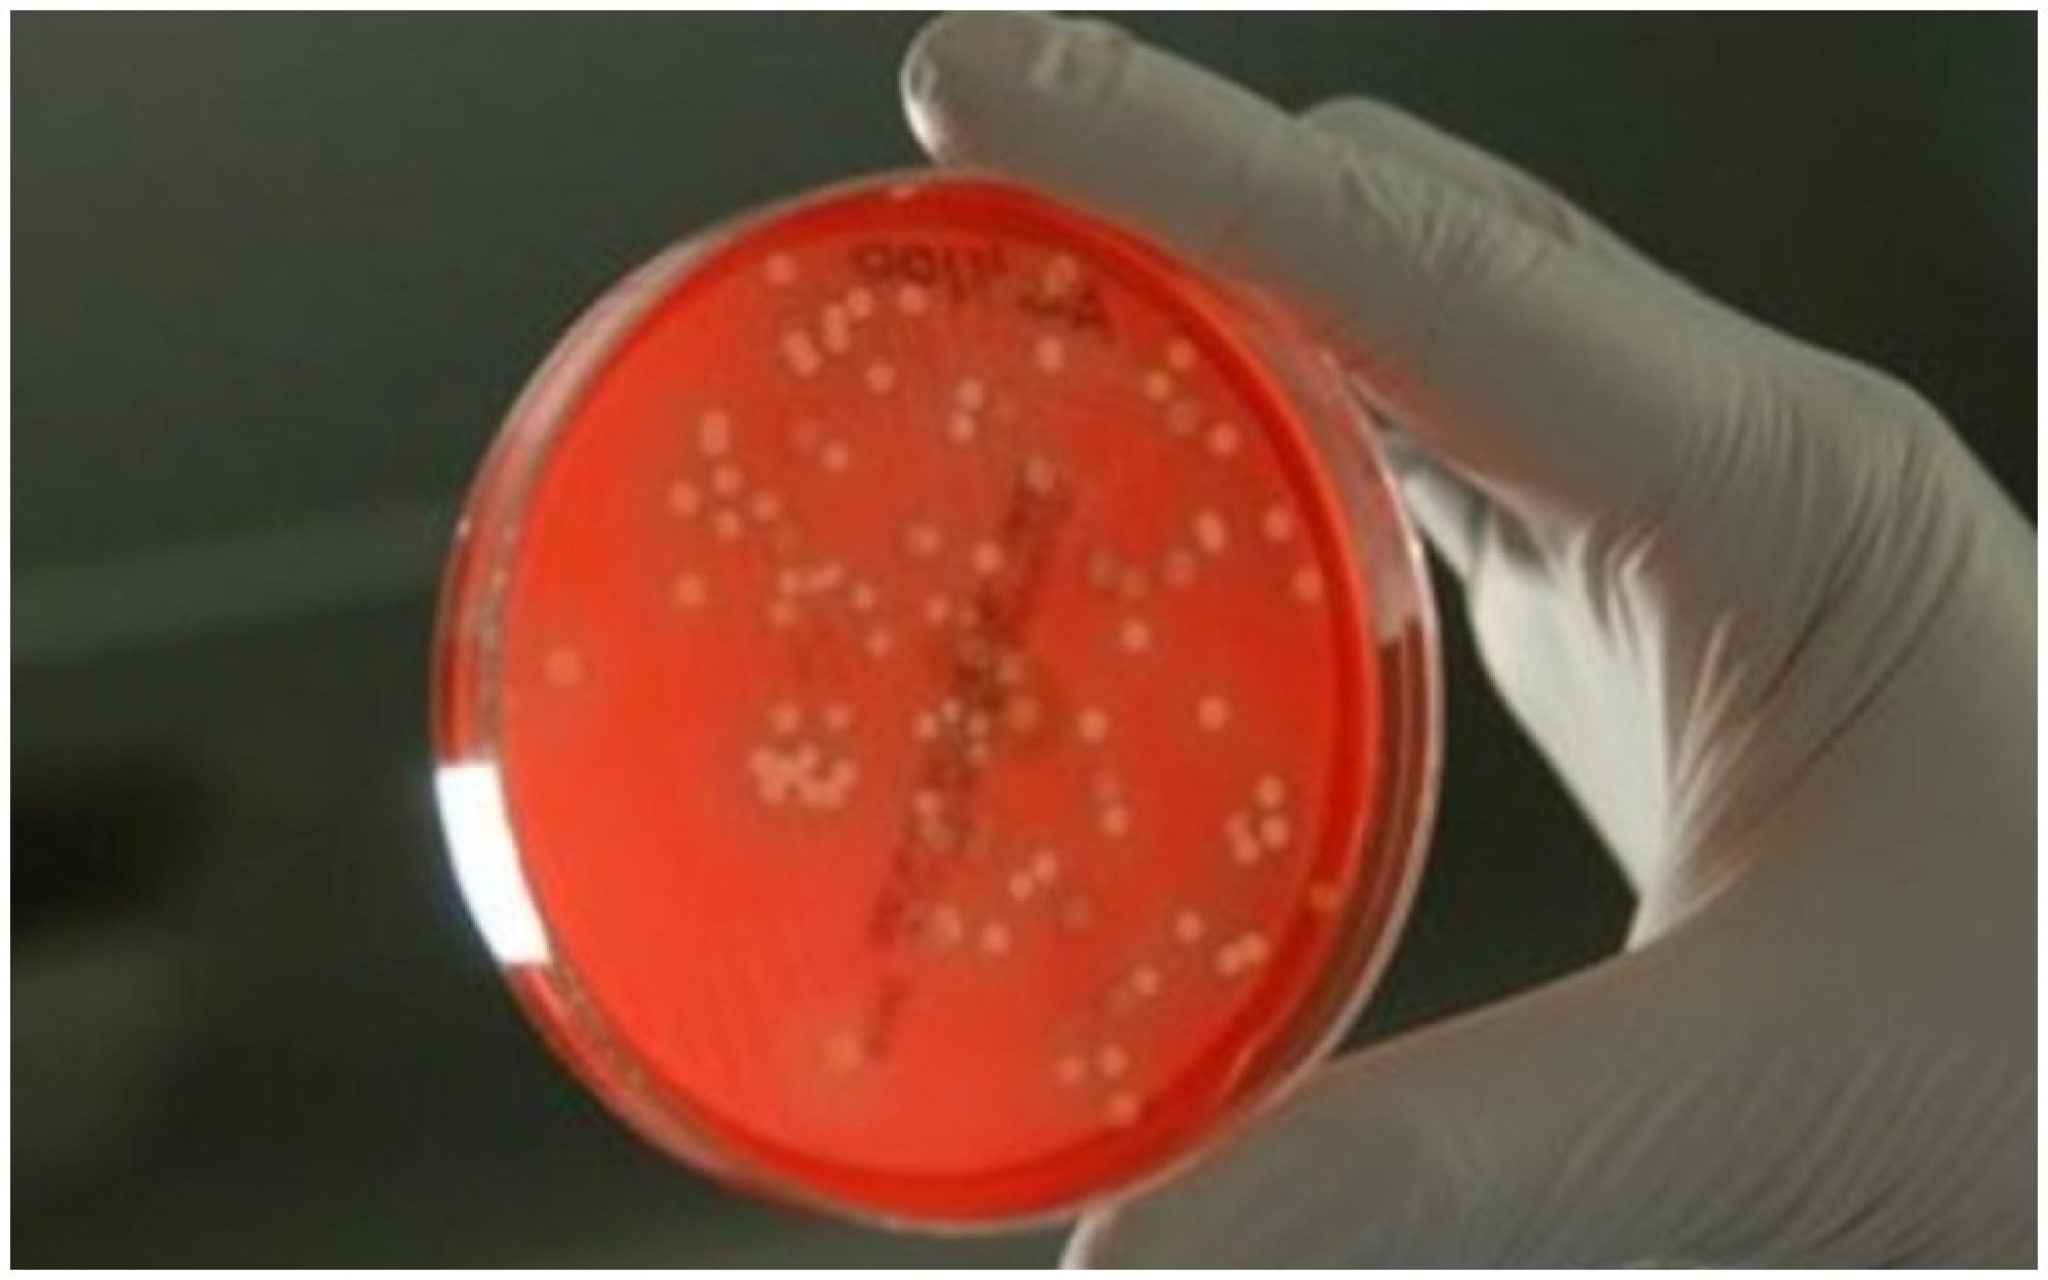
Korona
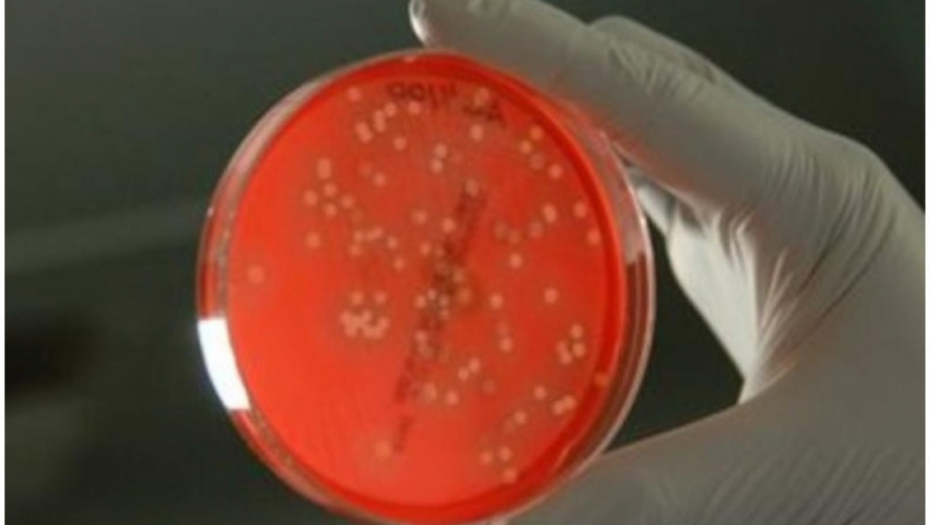
Korona

U Bosni i Hercegovini otkriven je britanski soj korona virusa
Printscreen/Youtube
U Bosni i Hercegovini otkriven je britanski soj korona virusa. Ovu informaciju su potvrdili na današnjoj konferenciji za novinare Kriznog štaba FBiH.
Nakon pozitivnog nalaza urađeno je sekvencioniranje virusa na Veterinarskom fakultetu u Sarajevu gde je ustanovljen soj koji do sada nije bio registrovan na tlu BiH.
Prof. dr Teufik Goletić sa Veterinarskog fakulteta je rekao da na svu sreću nema nove mutacije, koja nažalost izaziva slabiju efikasnost vakcina.
- Ovakve informacije mogu da znače puno u opredeljenju za nove mere. Evo konkretno znamo za britanski soj da se on širi 30 posto brže - saopštili su na konferenciji.
PROČITAJTE JOŠ: